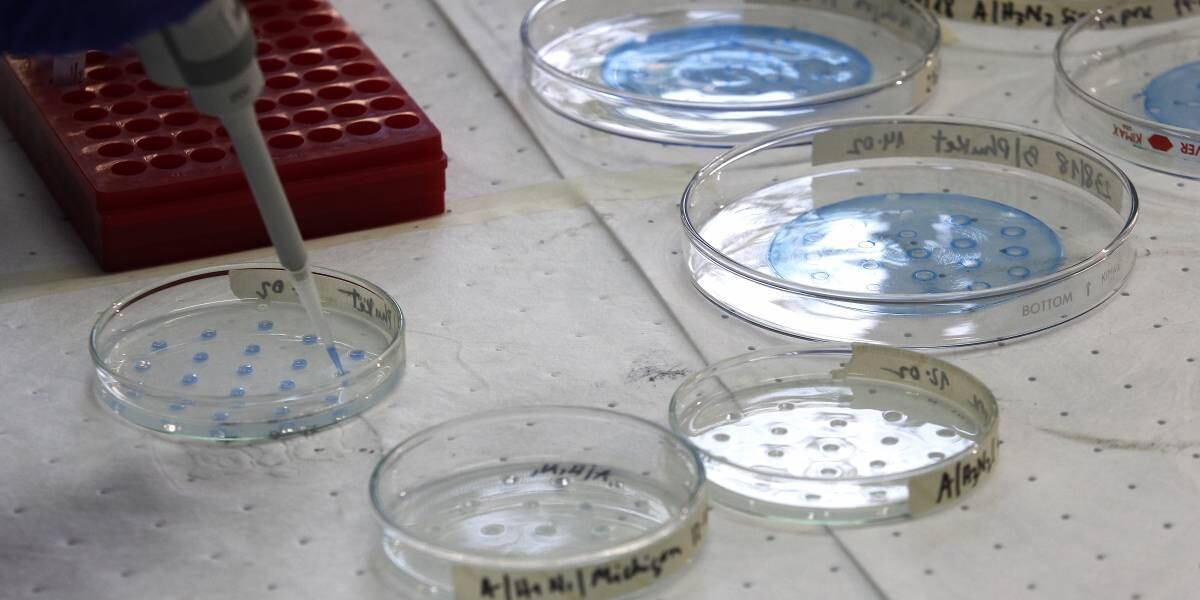

El Ministerio de Salud dio a conocer este jueves un nuevo reporte sobre los casos de coronavirus en Chile.
La subsecretaria de Salud Pública, Paula Daza, señaló que durante las últimas 24 horas se registraron 2.659 casos nuevos de covid-19.
De dicha cifra, 2.301 corresponden a personas que presentaron síntomas y 358 son asintomáticos.
Subsec @pdazan | Reporte diario #COVID_19
Informe de nuevos casos de las últimas 24 horas, hasta las 21:00 horas de ayer. pic.twitter.com/fzap3JL5zh
— Ministerio de Salud (@ministeriosalud) May 14, 2020
De esta manera, se contabilizan 37.040 casos de coronavirus desde que se inició la crisis.
La subsecretario señaló además que 15.655 personas se recuperaron del covid-19.
Subsec @pdazan | Reporte diario #COVID_19 pic.twitter.com/RYDHklS8Lt
— Ministerio de Salud (@ministeriosalud) May 14, 2020
Daza informó además el fallecimiento de 22 personas en las últimas 24 horas a causa del coronavirus. Al respecto, detalló que 18 son de la Región Metropolitana, dos de La Araucanía, una de Ñuble y una de Valparaíso.
De esta forma, se contabilizan 369 decesos desde que se inició la crisis.